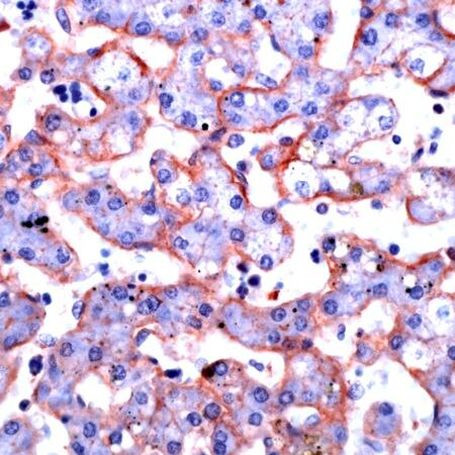
Annexin A6 Antibody in Immunohistochemistry (IHC)

Search
Invitrogen
Annexin A6 Polyclonal Antibody
{{$productOrderCtrl.translations['antibody.pdp.commerceCard.promotion.promotions']}}
{{$productOrderCtrl.translations['antibody.pdp.commerceCard.promotion.viewpromo']}}
{{$productOrderCtrl.translations['antibody.pdp.commerceCard.promotion.promocode']}}: {{promo.promoCode}} {{promo.promoTitle}} {{promo.promoDescription}}. {{$productOrderCtrl.translations['antibody.pdp.commerceCard.promotion.learnmore']}}
产品信息
PA5-32265
宿主/亚型
分类
类型
抗原
偶联物
形式
保存条件
运输条件
RRID
产品详细信息
This antibody is predicted to react with bovine, canine, mouse, porcine based on sequence homology.
Heat-mediated antigen retrieval is recommended prior to staining, using a 10mM citrate buffer, pH 6.0, for 10 minutes followed by cooling at room temperature for 20 min. Following antigen retrieval, incubate samples with primary antibody for 30 min at room temperature. A suggested positive control is liver tissue.
靶标信息
Annexin VI belongs to a family of calcium-dependent membrane and phospholipid binding proteins. Although their functions are still not clearly defined, several members of the annexin family have been implicated in membrane-related events along exocytotic and endocytotic pathways. The annexin VI gene is approximately 60 kbp long and contains 26 exons. It encodes a protein of about 68 kDa that consists of eight 68-amino acid repeats separated by linking sequences of variable lengths. It is highly similar to human annexins I and II sequences, each of which contain four such repeats. Exon 21 of annexin VI is alternatively spliced, giving rise to two isoforms that differ by a 6-amino acid insertion at the start of the seventh repeat. Annexin VI has been implicated in mediating the endosome aggregation and vesicle fusion in secreting epithelia during exocytosis.
仅用于科研。不用于诊断过程。未经明确授权不得转售。